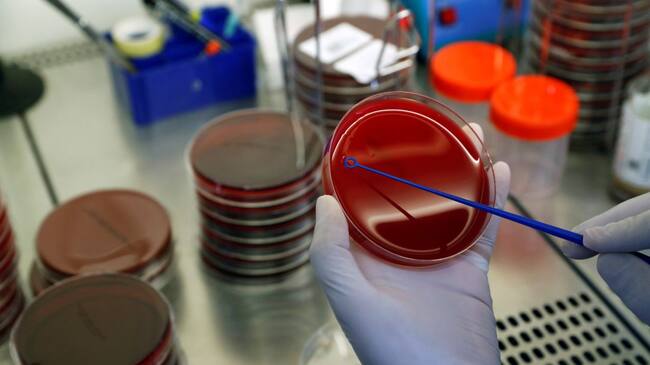

Un caso cada seis minutos en Valladolid
La provincia acumula una 'semana negra' con 937 positivos en cuatro días
Los últimos datos siguen arrojando cifras muy negativas / MURAD SEZER (Reuters)

Valladolid
En la misma semana en la que la Junta ha decidido dar por finalizadas las medidas de seguridad reforzadas en la capital, la pandemia deja algunos de los peores datos de la reciente historia del COVID-19. Durante los últimos cuatro días, se han confirmado 937 casos nuevos, una media de 234 cada día. O lo que es lo mismo, un caso cada seis minutos.
Hay que recordar que en la provincia hay tres localidades en situación de cuarentena. Son Íscar. Pedrajas, y Pesquera de Duero. Entre las tres suman casi 11.000 habitantes.
Además, la incidencia acumulada por zonas en la capital también deja cifras muy desiguales como los 22 casos por 10.000 habitantes de Covaresa o los 88 de Circunvalación. En el mapa de la Junta sólo hay zona en verde. Sigue siendo Villalón de Campos, sin un sólo caso registrado durante las últimas dos semanas.

Mario Alejandre
Valladolid, 1977. Licenciado en Ciencias de la Información por la Universidad Pontificia de Salamanca....




